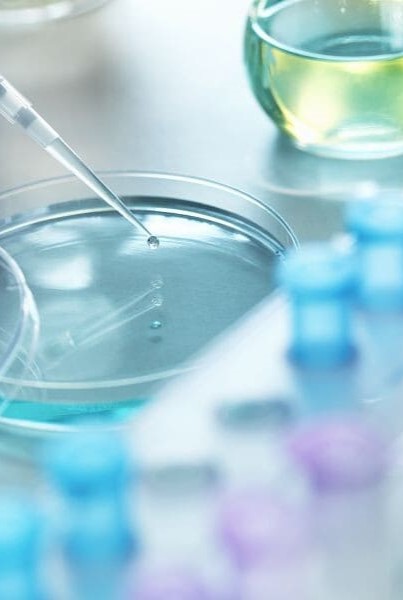
Chimique-Plastique

Chiffres clés
Nos réalisations en chiffres clés
Superficie totale aménagée pour le développement industriel
Entreprises industrielles en activité sur nos sites
Zones industrielles en développement actif
Postes directs générés par nos sites industriels
Montant total des investissements attirés
CA global des entreprises implantées
Actualités & News
Les dernières réalisations de l'APROSI

Accueil des élèves de l’ENA à l’APROSI : une immersion au cœur de l’action publique industrielle
Lire la suite
Visite du Directeur général de l’APROSI au Domaine Industriel de Diamniadio (DID)
Lire la suite
APROSI, partenaire de livraison des Jeux Olympiques de la Jeunesse Dakar 2026
Lire la suite
Inauguration de l’usine ISEVEM : une étape décisive vers la souveraineté industrielle et stratégique du Sénégal
Lire la suite
L’APROSI au cœur du panel sur la compétitivité industrielle et le produit local
Lire la suite
L’APROSI accompagne le Ministre de l’Industrie et du Commerce dans la visite des usines de la SONACOS à Diourbel et Kaolack
Lire la suite
L’APROSI participe à la campagne annuelle de sensibilisation au dépistage du cancer du sein
Lire la suite
Mission de l’APROSI en Turquie : Renforcement de la Coopération Industrielle et Promotion des Sites Sénégalais
Lire la suite
Salon Dakar Industries 2025 : L'APROSI présente sa stratégie pour concrétiser le « Produire et Consommer au Sénégal »
Lire la suiteInvestir dans nos Pôles Industriels
Crédibilité et stabilité
Une agence de l'État garantissant sécurité et pérennité
Infrastructures premium
Normes internationales garanties
Solutions foncières
Terrains viabilisés en vente ou location
Sécurité juridique
Droit réel sur votre patrimoine immobilier
Solutions clés en main
Bâtiments prêts à l'emploi
Flexibilité spatiale
Plateaux de bureaux modulables
Connectivité optimale
Réseau logistique performant
Énergie fiable
Approvisionnement varié et sécurisé
Simplification administrative
Guichet unique pour vos démarches
Position stratégique
Géographie optimale pour votre business
Main d'œuvre qualifiée
Compétences exceptionnelles et compétitives
Cadre de vie exceptionnel
Environnement agréable et optimisé
Avantages douaniers
Régime spécial pour votre compétitivité
Fiscalité attractive
Régime conçu pour votre rentabilité
Liberté financière
Régime des changes sans restriction
Secteurs d'Activités
Ils nous ont fait confiance
Nos champions
Les Pôles Industriels

Pôle de Dakar
Centre de services à haute valeur ajoutée et carrefour culturel de rang international.
Pôle Thies
Axe stratégique pour les industries extractives, l'agro-industrie, et le tourisme balnéaire.
Pôle Centre
Modèle de développement durable axé sur son riche patrimoine naturel et sa position stratégique.
Pôle Diourbel-Louga
Pôle urbain et industriel majeur avec une forte identité religieuse d'envergure mondiale.
Pôle Nord
Zone agro-industrielle compétitive et destination touristique prisée.
Pôle Sud
Plateforme agro-industrielle régionale et pôle de tourisme durable.
Pôle Nord-Est
Pôle industriel axé sur la production d'engrais et un bassin agropastoral moderne.
Pôle Sud-Est
Bassin économique diversifié, aujourd'hui enclavé, avec un potentiel immense.
Nos Réalisations
Découvrez nos projets phares qui redéfinissent l'industrie

FAQ
Trouvez des réponses à vos questions sur l'acquisition de nos sites industriels
L'APROSI est la seule agence étatique mandatée par décret pour aménager et promouvoir des sites industriels au Sénégal.
Un terrain industriel est un espace réservé aux activités industrielles (textile, automobile, métallurgie, etc.) caractérisé par :
- De grandes superficies disponibles
- Une localisation stratégique
- Un excellent accès aux réseaux de transport
- Des infrastructures adaptées
Pour constituer votre dossier, vous devez fournir :
- Statuts de l'entreprise
- Registre de commerce (RC)
- NINEA
- Business Plan complet
- Étude d'impact environnemental
- Demande d'affectation signée
Tous les promoteurs et investisseurs intéressés par un développement industriel au Sénégal
Entreprises locales et internationales
Opérateurs économiques de tous secteurs industriels
Contrat de réservation
Document officiel attestant de votre réservation
Acte notarié
Document légal signé devant notaire
- Agrément au code des investissements
- Exonération de l'IS (15%)
- Réduction du bénéfice imposable
- Avantages douaniers
- Tarifs préférentiels sur les facteurs de production
- Bâtiments clés en main disponibles
- Tarifs très compétitifs
- Équipements modernes
- Réseaux d'infrastructures performants
Dépôt du dossier
Jour 0 - Soumission complète de votre demande
Instruction
Jours 1 à 7 - Vérification des pièces
Validation
Jours 8 à 14 - Approbation par la commission
Finalisation
Jours 15 à 30 - Signature des documents
Vous avez d'autres questions?
Notre équipe est à votre disposition pour vous accompagner
Contactez-nousLocalisation Stratégique
Plateforme Industrielle Internationale de Diamniadio, Sénégal
Position Centrale
Implanté au cœur du Pôle Urbain de Diamniadio, à seulement 30 km de Dakar, avec un accès direct à l'autoroute à péage et à l'aéroport international Blaise Diagne.
Infrastructures Modernes
Zone équipée en réseaux haute capacité (électricité, eau industrielle, fibre optique) et à proximité immédiate de la Cité Administrative de l'État.
Avantages Fiscaux
Bénéficiez des avantages de la Zone Économique Spéciale (ZES) avec des exonérations fiscales et des procédures administratives simplifiées.
Hub Multimodal
Connecté aux ports de Dakar et du futur Ndayane, ainsi qu'au réseau ferroviaire régional, offrant des solutions logistiques complètes.
Vous souhaitez découvrir les opportunités d'implantation sur notre plateforme ?
Planifier une visite